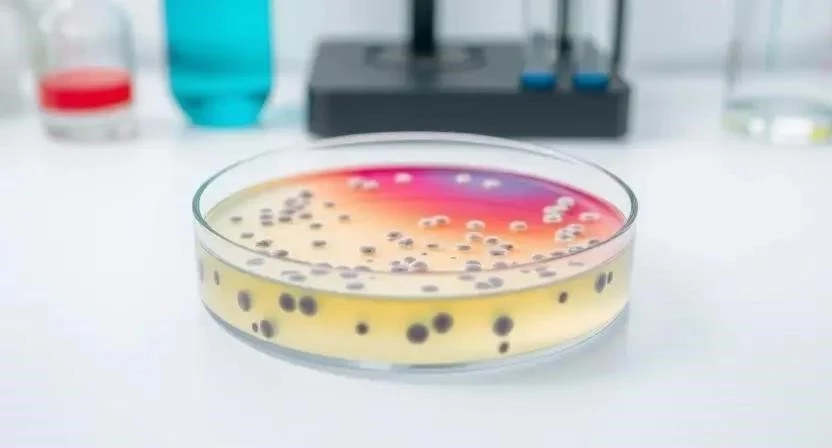

Задумывались ли вы когда-нибудь, кто следит за тем, чтобы продукты, которые мы едим, вода, которую мы пьем, и воздух, которым мы дышим, были безопасными? Санитарно-эпидемиологический контроль – это как невидимый щит, оберегающий наше здоровье и благополучие. По статистике, соблюдение санитарных норм снижает заболеваемость инфекционными болезнями на 30-40%. Ключевое слово – санитарно-эпидемиологический контроль. Понимание принципов его работы – это первый шаг к осознанному отношению к своему здоровью и окружающей среде.
- Определение и цели
- Объекты контроля
- Органы контроля
- Методы контроля
- Санитарно-эпидемиологическая экспертиза
- Профилактика инфекционных заболеваний
- Права и обязанности
- Ответственность за нарушения
- FAQ
- Таблица 1: Объекты санитарно-эпидемиологического контроля
- Таблица 2: Органы, осуществляющие контроль
- Таблица 3: Методы контроля и их применение
Определение и цели
Санитарно-эпидемиологический контроль – это система мероприятий, направленных на предотвращение возникновения и распространения заболеваний, а также на обеспечение безопасности для жизни и здоровья человека. Его основная цель – защита здоровья населения от негативного воздействия факторов окружающей среды и поддержание санитарно-эпидемиологического благополучия. Задачи контроля включают в себя выявление и устранение факторов риска, проведение профилактических мероприятий, а также контроль за соблюдением санитарных норм и правил.
Объекты контроля
Санитарно-эпидемиологическому контролю подлежат самые разные объекты, от продовольственных товаров и воды до воздуха на рабочих местах и общественных местах. Это включает в себя предприятия общественного питания, образовательные учреждения, медицинские организации, объекты жилищно-коммунального хозяйства, транспорт и многое другое. Контролируется качество продукции, соблюдение санитарных норм при производстве и реализации товаров, а также состояние окружающей среды. Я помню, как однажды, работая над проектом по оценке рисков, мы столкнулись с необходимостью проверки санитарного состояния небольшого кафе. Выявили ряд нарушений, которые могли привести к пищевому отравлению, и помогли владельцам устранить их.
Органы контроля
Основным органом, осуществляющим санитарно-эпидемиологический контроль в Российской Федерации, является Федеральная служба по надзору в сфере защиты прав потребителей и благополучия человека – Роспотребнадзор. Также важную роль играют Федеральные бюджетные учреждения здравоохранения (ФБУЗ), такие как Федеральный центр гигиены и эпидемиологии (ФЦГиЭ). Роспотребнадзор осуществляет надзорную деятельность, разрабатывает санитарные правила и нормы, а ФЦГиЭ проводит лабораторные исследования и экспертизы. Недавно я участвовал в совещании, где обсуждались вопросы взаимодействия Роспотребнадзора и ФЦГиЭ по вопросам контроля за качеством питьевой воды.
Методы контроля
В санитарно-эпидемиологическом контроле используется широкий спектр методов, включая экспертизу, лабораторные исследования, мониторинг и проверки. Экспертиза позволяет оценить соответствие продукции или услуг установленным требованиям. Лабораторные исследования проводятся для выявления опасных микроорганизмов, химических веществ и других загрязнителей. Мониторинг позволяет отслеживать изменения санитарно-эпидемиологической обстановки. Проверки проводятся для выявления нарушений санитарных норм и правил. Например, при проверке предприятия пищевой промышленности мы проводим отбор проб продукции для лабораторных исследований, а также проверяем соблюдение санитарных правил персоналом.
Санитарно-эпидемиологическая экспертиза
Санитарно-эпидемиологическая экспертиза – это процесс оценки соответствия продукции или услуг санитарным нормам и правилам. Существует несколько видов экспертиз, включая гигиеническую, эпидемиологическую и экологическую. Гигиеническая экспертиза оценивает влияние продукции или услуг на здоровье человека. Эпидемиологическая экспертиза оценивает риск возникновения и распространения инфекционных заболеваний. Экологическая экспертиза оценивает влияние продукции или услуг на окружающую среду. Я помню случай, когда нам пришлось проводить экспертизу новой партии детских игрушек. Выявили превышение допустимого содержания вредных веществ и запретили реализацию этой партии.
Профилактика инфекционных заболеваний
Санитарно-эпидемиологический контроль играет ключевую роль в профилактике инфекционных заболеваний. Он включает в себя мероприятия по дезинфекции, дезинсекции, дератизации, вакцинации, а также контроль за соблюдением санитарных норм в медицинских организациях и других учреждениях. Важным аспектом является санитарное просвещение населения, направленное на повышение осведомленности о мерах профилактики инфекционных заболеваний. Например, во время эпидемии гриппа мы проводили рейды по школам и детским садам, проверяя соблюдение санитарных норм и правил.
Права и обязанности
Контролирующие органы имеют право проводить проверки, запрашивать документы, отбирать пробы продукции для исследований, выдавать предписания об устранении нарушений и применять санкции. Контролируемые субъекты обязаны предоставлять необходимую информацию, выполнять предписания контролирующих органов и соблюдать санитарные нормы и правила. Важно помнить, что соблюдение санитарных требований – это не только обязанность, но и вклад в собственное здоровье и благополучие.
Ответственность за нарушения
Нарушение санитарно-эпидемиологических требований влечет за собой административную, а в некоторых случаях – уголовную ответственность. Размер штрафов зависит от характера и степени тяжести нарушения. В случае причинения вреда здоровью человека виновные лица могут быть привлечены к уголовной ответственности. Я считаю, что строгая ответственность за нарушения санитарных норм – это необходимая мера для обеспечения безопасности населения.

FAQ
Вопрос: Что такое санитарно-эпидемиологическое благополучие?
Ответ: Это состояние окружающей среды и факторы, которые не оказывают вредного воздействия на здоровье человека.
Вопрос: Какие документы необходимо предоставить при проверке Роспотребнадзора?
Ответ: Перечень документов зависит от вида деятельности организации, но обычно включает в себя учредительные документы, лицензии, разрешения, санитарно-эпидемиологические заключения и другие документы, подтверждающие соответствие деятельности санитарным нормам и правилам.
Вопрос: Что делать, если я получил предписание об устранении нарушений?
Ответ: Необходимо в установленный срок устранить нарушения и предоставить контролирующему органу подтверждение об их устранении.
Таблица 1: Объекты санитарно-эпидемиологического контроля
| Объект контроля | Характеристика | Примечания |
|—|—|—|
| Предприятия общественного питания | Кафе, рестораны, столовые | Контроль за соблюдением санитарных норм при приготовлении и реализации пищи |
| Образовательные учреждения | Школы, детские сады, вузы | Контроль за состоянием помещений, качеством питания, соблюдением санитарных норм |
| Медицинские организации | Больницы, поликлиники, стоматологии | Контроль за соблюдением санитарно-эпидемиологического режима, стерилизацией инструментов |
| Объекты жилищно-коммунального хозяйства | Водопроводные станции, канализационные сети, мусорные полигоны | Контроль за качеством воды, состоянием канализационных сетей, соблюдением санитарных норм при обращении с отходами |
| Транспорт | Автобусы, поезда, самолеты | Контроль за соблюдением санитарных норм при перевозке пассажиров |
Таблица 2: Органы, осуществляющие контроль
| Орган контроля | Функции |
|—|—|
| Роспотребнадзор | Осуществление государственного санитарно-эпидемиологического надзора и контроля |
| ФЦГиЭ | Проведение лабораторных исследований и экспертиз |
| Региональные управления Роспотребнадзора | Осуществление контроля на территории субъектов Российской Федерации |
| Территориальные органы Роспотребнадзора | Осуществление контроля на территории городов и районов |
Таблица 3: Методы контроля и их применение
| Метод контроля | Применение |
|—|—|
| Экспертиза | Оценка соответствия продукции или услуг санитарным нормам |
| Лабораторные исследования | Выявление опасных микроорганизмов, химических веществ и других загрязнителей |
| Мониторинг | Отслеживание изменений санитарно-эпидемиологической обстановки |
| Проверки | Выявление нарушений санитарных норм и правил |
